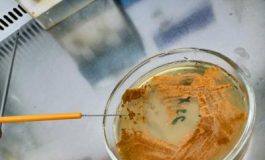
featured 2214071 265x160

Pediatri italiani si fermano in ricordo dei 9 figli della collega di Gaza
Roma, 26 mag. (Adnkronos Salute) - La notizia dell'attacco missilistico che ha colpito "l'abitazione di una collega pediatra nella Striscia di Gaza", con la morte di 9 figli, "ha scosso tutta la Federazione italiana medici pediatri (Fimp)", dichiara Antonio D'Avino...